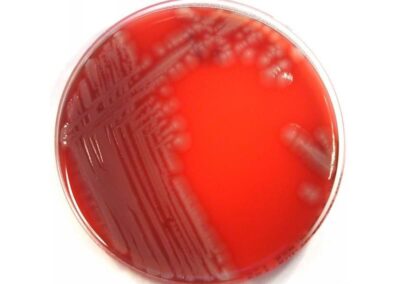
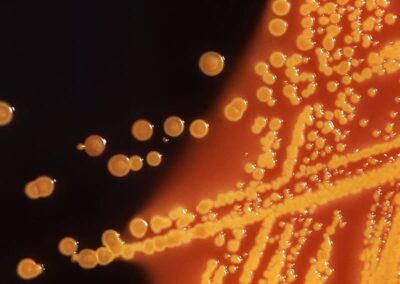
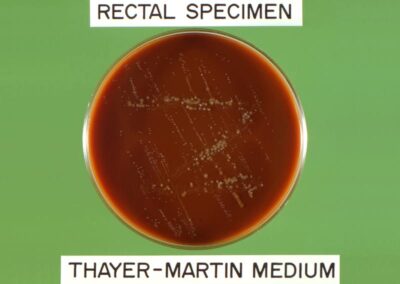
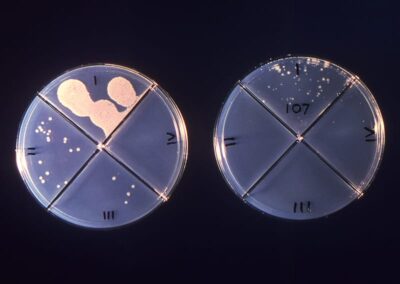

Die Prostatitis
Entzündung der Prostata.
ICD-10: N41.1
Wir lösen Ihr Problem des Prostataentzündung
Die Prostatitis ist eine Entzündung der Prostata (Vorsteherdrüse). Bakterien gelangen in die Prostata durch das Blut oder den Samenleiter. Die Prostata hat sehr enge Kanäle. Dadurch ist die Durchblutung begrenzt. Demzufolge ist eine Therapie durch Medikamente schwierig. Kälte kann eine Prostataentzündung begünstigen. 2-10% der männlichen Bevölkerung erkranken an Prostatitis.

© Harry Cunningham / unsplash.com
%
der männlichen Bevölkerung erkranken an Prostatitis.
Der Zusammenhang zwischen Prostatitis und männlicher Infertilität ist derzeit nicht bewiesen, jedoch leiden Patienten mit chronischer Prostatitis häufiger an einer erektilen Dysfunktion. Es gibt keinen Zusammenhang zwischen Prostataentzündung und Prostatakarzinom, obwohl 10% der Prostatakarzinompatienten zuvor bereits eine Prostatitis hatten. Die Beschwerden sind häufige Blasenentleerung, Schmerzen und Brennen beim Wasserlassen, Harndrang, stichartige Schmerzen im Damm, Penis, Hoden und Schambereich und Schmerzen bei der Ejakulation.
Für wen ist die Behandlung angezeigt?
Die Behandlung der Prostatitis erfolgt nach Erhebung der Anamnese, Ultraschalluntersuchung der Prostata und Untersuchung des Urins und der Spermien. Danach sind Antibiotika nur entsprechend eines Nachweises von Bakterien im Sperma zu verabreichen. Patienten die unter einer nicht-bakteriellen Prostataentzündung leiden, bekommen abschwellende Medikamente und Schmerzmittel. Chronische Prostatitis und wiederkehrende Prostatitis (rezidivierende Erkrankung) sind zusätzlich mit physikalischen Methoden zu behandeln.
Wie gestaltet sich der Behandlungsablauf?
Was Sie vor der chronischen Prostatitis beachten sollten
Prostatitis wird meistens durch E. coli (Darmbakterien) verursacht. Manchmal sind auch N. gonorrhoeae, Chlamydien, Trichomonaden und seltener M. tuberculosis verantwortlich.
Folglich ist es erforderlich, eine Kultur anzulegen, um den entzündungserregenden Mikroorganismus ausfindig zu machen. Zudem sind meisten die Anamnese, Untersuchung der Prostata mittels Ultraschall, eine digitale rektale Untersuchung, Urin- und Sperma-Untersuchung sowie eine Blutanalyse erforderlich.
Eichelvergrößerung wiederherstellt die Relation zwischen die Eichel und das Glied.

© Dr. Aref Elseweifi / masculine.de
Die Entzündungserreger sind:
- E. coli
- Neisseria gonorrhoeae
- Chlamydia
- Trichomonaden
- Mycobacterium tuberculosis
www.wikipedia.org (3, 4, 5, 6, 7, 8, 9, 10, 11, 12, 13, 14, 15, 16)
Wie wird die Behandlung der akuten bzw. chronischen Prostatitis durchgeführt?
Schritt 1:
Der Hodensack wird vorsichtig geweitet und die vorab bestimmte Silikonprothese wird implantiert.
Akute Prostatitis wird mit folgenden Antibiotika therapiert:
- Gyrasehemmern
- Tetracykline
Hingegen eigenen sich folgenden Antibiotika für die chronische Prostatitis:
<ul“>
- Gyrasehemmern
- Tetracykline
empty
Wie lange dauert die Behandlung?
Wie lange dauert die Heilungsphase?
Wie lange besteht Arbeitsunfähigkeit?
Welche Einschränkungen (Narben, Schwellungen, usw.) bringt die Behandlung mit sich?
Sie können Ihre Operation über medipay finanzieren.
Informieren Sie sich jetzt: 0 22 41 / 96 9 26-0
Operation auf einen Blick
Die Prostatitis
Operation
| : Genesung | 10-15 Tage ambulant |
|---|---|
| : Operation Dauer | keine außer wenn Blasenhalsenge oder Harnröhrenenge vorhanden. |
| : Narkose | keine |
Vor und Nachsorge
| : Vorbereitung | keine |
|---|---|
| : Ausfallzeit | 1-2 Woche |
| : Nachsorge | 1 Tag / am 7ten Tag und 4 Wochen danach dann nur wenn Beschwerden sich wiederholen. |
| : Sexuelle Aktivität | 2 Wochen Abstinenz |
| : Sport & Sonnenbaden | Sport und Schwimmen normal. |
| : Termin | 14 Tage im Voraus außer bei akuter Entzündung. |
| : Betreuung am Heimatort | Erforderliche postoperative Betreuung bis zu der vollen Heilung |
Kosten
| Privatversicherung: | Wird nach GOÄ je Schweregrad der Operation berechnet. |
|---|---|
| Selbstzahler | |
| : Operation | Behandlung-Kostenvoranschlag |
| : Narkose | |
| allgemeine | 380 €* je angefangene Stunde. |
| örtliche | 250 €* je angefangene Stunde. |
| : Übernachtung | 300 €* |
| Eine Ratenzahlung ist möglich. Wir arbeiten mit dem Finanzierungspartner Medipay zusammen. Sprechen Sie uns an. | |
| Kassenversicherung: | keine zusätzliche Zahlung. |
| 100 €* Stornierungsgebühr bei Absage bis 2 Wochen vor OP bzw. |
* Alle Preise sind Nettoangaben und verstehen sich zzgl. der gesetzlichen Mehrwertsteuer. |
|---|---|
| 500 €* Gebühr bei Absage unter 2 Wochen vor OP° |
° Die Stornierungsgebühren werden wegen des administrativen Aufwands erhoben. Die Rechnungen werden für absolute Transparenz nach der Gebührenordnung für Ärzte (GOÄ) auch mit analogen Ziffern erstellt, falls erforderlich. |
masculine — — Praxis für Urologie
Nachsorge
Die Erwartungen nach der Behandlung des Prostatitis.
wann wird das Ergebnis der Behandlung der Prostatitis sichtbar sein?
Eine Erleichterung spüren Sie bereits eine Woche nach der Einnahme der Medikamente. Dennoch ist es wichtig, Antibiotika so lange wie verschrieben einzunehmen, damit sich keine Resistenz entwickelt.
Wie lange hält das Ergebnis an?
Die Therapie wirkt unterschiedlich lang. Die Symptome treten in 50% der Fälle wieder auf.

© Taisiia Stupak / unsplash.com
Komplikationen
nach der Behandlung der Prostatitis
Welche Probleme können auftreten?
Was ist nach der Behandlung zu vermeiden?
- Kälte
- Sitzen auf einem harten Stuhl
- Harten Stuhlgang
- Geschlechtsverkehr
Welche Komplikationen können während der Heilungsphase der Prostatitis auftreten?
Wie können Sie die Heilung beschleunigen?
Es ist so ratsamer |
|||
|---|---|---|---|
|
Ein Antibiotikum bis zu 10 Tage lang einzunehmen. Den Verband für 10 Tage nach der Operation täglich zu wechseln. |
|||
|
Baden und Schwimmen |
|||
Because health is life – FAQ—Nachsorge |
|||
Sie können die eventuellen Komplikationen Ihre Operation durch engmaschige postoperative Kontrolle bei Ihrem Arzt vermeiden.
Kontraindikationen
Was sind Kontraindikationen bei Prostatitis?
In welchen Fällen kann die Behandlung der Prostatitis nicht durchgeführt werden?
Die bakterielle Prostatitis behandelt man mit Antibiotika, jedoch sind Antibiotika bei einer nicht-bakteriellen Prostatitis kontraindiziert.
© Rawpixel / unsplash.com
Die Prostataentzündung auf einen Blick,
Zusammenfassung und Schlusswort von Dr.med. Elseweifi
Abwägung der Risiken, Vorteile und Nachteile des Behandlung der Prostatitis
Prostatitis ist eine meistens chronische Erkrankung des jungen Mannes welche unangenehme Schmerzen sowohl am Damm als auch am Penis verursacht. Die Erkrankung muss mit Wärme und Antibiotika behandelt werden. Hingegen wird eine nicht-bakterielle Prostatitis von Dr. Elseweifi nur symptomatisch behandelt. Die Prostatitis verursacht in seltenen Fällen eine Potenzstörung, jedoch ist deren Einfluss auf die Fertilität noch nicht erwiesen.
Gibt es eine alternative Behandlung mit dem gleichen Effekt?
Nein. Die Behandlung ist lediglich medikamentös und physikalisch.
Eichelvergrößerung wiederherstellt die Relation zwischen die Eichel und das Glied.
Quelle
Prostataentzündung
prostate — простата — 前列腺 — البروستات — Prostata